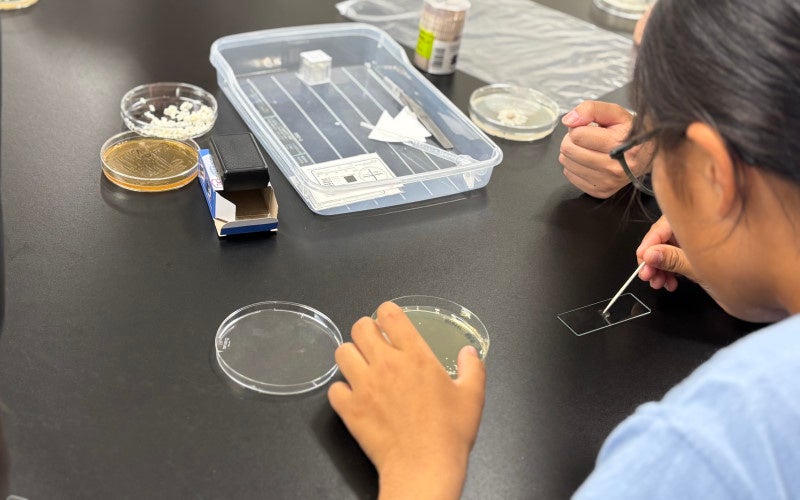

【岡山大学】科学の未来を担う中学生・高校生を対象に「2025サイエンストライアル」を開催

2025(令和7)年 10月 21日
国立大学法人岡山大学
◆概 要
国立大学法人岡山大学(本部:岡山市北区、学長:那須保友)の岡山大学ダイバーシティ推進本部男女共同参画室は、2025年10月4日、最先端の研究の内容を実際に体験する「サイエンストライアル」を開催し、岡山県内外の中学生、高校生合計19人が参加しました。
はじめに、講師を務めた学術研究院環境生命自然科学学域(農)の小野千由貴助教(特任)から、身の回りにはたくさんの微生物がいることや菌の種類、役割などについて説明がありました。
次に、大学生8人が自身の研究内容や大学生活、趣味や特技について個性あふれる表現で自己紹介。その後、クイズ形式で、発酵食品や酵母、乳酸菌などについてわかりやすく説明がありました。
顕微鏡を使った実験では、参加者が、パン、納豆、味噌などに含まれる微生物のにおいを確認したり、肉眼では見えない微生物を大学生と一緒に楽しく観察していました。
参加者からは「酵母が日常でどのように活用されているか知ることができたことが感慨深かった」、「クイズ形式で分かりやすかった」、「顕微鏡の使い方を丁寧に説明してくれて分かりやすかった」などの感想が寄せられました。また、「大学生の自己紹介や大学生との交流が楽しかった」、「生物、化学の面白さに気付きました」など、大学への興味・進路選択の参考につながったとの感想も多く寄せられました。引き続き、地域中核・特色ある研究大学:岡山大学の取り組みにご期待ください。

◆参 考
・岡山大学ダイバーシティ推進本部男女共同参画室
https://okayama-u-diversity.jp/diversity-hub/gender-equality-office/
・岡山大学Instagram
https://www.instagram.com/p/DP2-rURgECf/
・岡山大学YouTube
https://www.youtube.com/watch?v=PdBthknYqOY



◆本件お問い合わせ先
岡山大学 総務部 ダイバーシティ推進課
〒700-8530 岡山県岡山市北区津島中1-1-1 岡山大学津島キャンパス
TEL:086-251-8987
https://www.okayama-u.ac.jp/tp/news/news_id14695.html
<岡山大学病院との連携等に関する件(製薬・医療機器企業関係者の方)>
岡山大学病院 新医療研究開発センター
〒700-8558 岡山県岡山市北区鹿田町2-5-1
下記URLより該当する案件についてお問い合わせください
http://shin-iryo.hospital.okayama-u.ac.jp/ph_company/
<岡山大学病院との連携等に関する件(医療関係者・研究者の方)>
岡山大学病院 研究推進課 産学官連携推進担当
〒700-8558 岡山県岡山市北区鹿田町2-5-1
TEL:086-235-7983
E-mail:ouh-csnw◎adm.okayama-u.ac.jp
※ ◎を@に置き換えて下さい
http://shin-iryo.hospital.okayama-u.ac.jp/medical/
<岡山大学の産学官連携などに関するお問い合わせ先>
岡山大学研究・イノベーション共創機構 産学官連携本部
〒700-8530 岡山県岡山市北区津島中1-1-1 岡山大学津島キャンパス 本部棟1階
TEL:086-251-8463
E-mail:sangaku◎okayama-u.ac.jp
※ ◎を@に置き換えて下さい
https://www.orsd.okayama-u.ac.jp/
<岡山大学の研究機器共用(コアファシリティ)などに関するお問い合わせ先>
岡山大学研究機器の共用の体制・整備等の強化促進に関するタスクフォース(略称:チーム共用)
〒700-8530 岡山県岡山市北区津島中1-1-1 岡山大学津島キャンパス 本部棟1階
TEL:086-251-8705
FAX:086-251-7114
E-mail:cfp◎okayama-u.ac.jp
※ ◎を@に置き換えて下さい
https://corefacility-potal.fsp.okayama-u.ac.jp/
<岡山大学のスタートアップ・ベンチャーなどに関するお問い合わせ先>
岡山大学研究・イノベーション共創機構 スタートアップ・ベンチャー創出本部
〒700-8530 岡山県岡山市北区津島中1-1-1 岡山大学津島キャンパス 本部棟1階
E-mail:start-up1◎adm.okayama-u.ac.jp
※ ◎を@に置き換えて下さい
https://venture.okayama-u.ac.jp/
岡山大学メディア「OTD」(アプリ):https://prtimes.jp/main/html/rd/p/000000011.000072793.html
岡山大学メディア「OTD」(ウェブ):https://prtimes.jp/main/html/rd/p/000000215.000072793.html
岡山大学オリジナルグッズ Online Shop:https://okadaigoods.official.ec/
岡山大学統合報告書2024:https://prtimes.jp/main/html/rd/p/000002801.000072793.html
岡山大学SDGsホームページ:https://sdgs.okayama-u.ac.jp/
岡山大学SDGs~地域社会の持続可能性を考える(YouTube):https://youtu.be/Qdqjy4mw4ik
岡山大学Image Movie (YouTube):https://youtu.be/pKMHm4XJLtw
岡山大学地域中核・特色ある研究大学強化促進事業(J-PEAKS):https://j-peaks.orsd.okayama-u.ac.jp/
産学共創活動「岡山大学オープンイノベーションチャレンジ」2025年10月期共創活動パートナー募集中:https://prtimes.jp/main/html/rd/p/000003423.000072793.html


国立大学法人岡山大学は、国連の「持続可能な開発目標(SDGs)」を支援しています。また、政府の第1回「ジャパンSDGsアワード」特別賞を受賞しています。地域中核・特色ある研究大学として共育共創を進める岡山大学にご期待ください
-
岡山大学 文部科学省「地域中核・特色ある研究大学強化促進事業(J-PEAKS)」に採択~地域と地球の未来を共創し、世界の革新の中核となる研究大学:岡山大学の実現を加速とともに世界に誇れる我が国の研究大学の山脈を築く~

すべての画像
